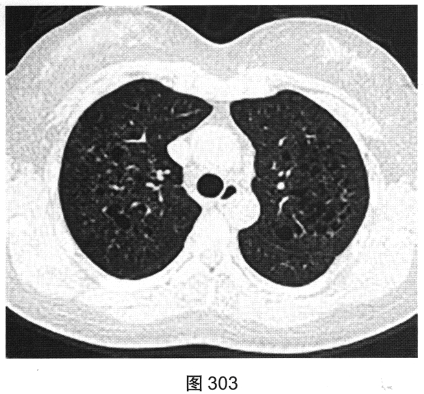
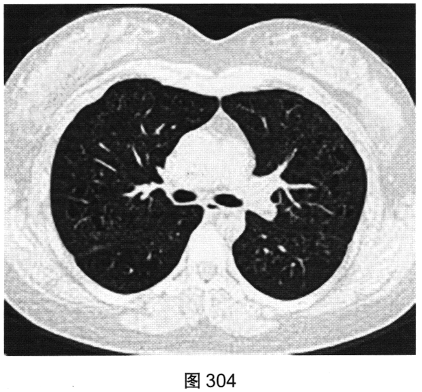

试题详情
- [材料题] 患者女性,32岁,因“间断刺激性干咳1年,发现肺部囊性病变8个月”就诊。患者无发热、咯血、胸痛、呼吸困难。服甘草片、阿莫西林无明显好转。胸部HRCT如图302~图307所示。

- 多项选择题1.患者胸部HRCT的阳性征象有( )
A、牵引性支气管扩张
B、磨玻璃样密度影
C、实变影
D、蜂窝影
E、弥漫性微小结节
F、小叶间隔增厚
G、多发囊状透光区
关注下方微信公众号,搜题查看答案

- 多项选择题2.影像检查所示肺内主要病变的形态、分布特点为( )
A、囊状透亮影形状不规则、大小不一
B、囊状病变与支气管相连
C、囊状透亮影形状规则,大小及肺内分布均匀
D、多发结节、磨玻璃影及囊状透亮影,以中上叶分布为著
E、结节主要表现为小叶中心性结节
F、囊壁厚而较规则
G、囊壁较薄、略欠均匀,部分囊壁欠连续
关注下方微信公众号,搜题查看答案

- 多项选择题3.可表现为肺内多发囊状透亮影的是( )
A、支气管扩张
B、淋巴细胞性间质性肺炎
C、特发性肺间质纤维化
D、肺朗格罕细胞组织细胞增生症
E、肺淋巴管平滑肌瘤病
F、肺气肿
关注下方微信公众号,搜题查看答案

- 多项选择题4.[提示]患者有长期吸烟史,已戒烟1年; 血ESR、CRP(一),血嗜酸性粒细胞(一), 血免疫球蛋白、免疫固定电泳及VEGF-D(一),ANA、ANCA(一); 抗dsDNA(一);腹部超声未见明显异常; 肺通气功能正常。给予拜复乐抗感染、沐舒坦化痰等对症治疗,咳嗽症状略缓解。结合患者临床及CT表现, 首先考虑诊断为( )
A、肺淋巴管平滑肌瘤病
B、肺朗格罕细胞组织细胞增生症
C、过敏性肺炎
D、淋巴细胞性间质性肺炎
E、特发性肺间质纤维化
F、囊状支气管扩张伴肺部感染
关注下方微信公众号,搜题查看答案

热门试题
- 支气管肺炎的CT表现包括A、可形成空洞B
- 1、最可能的诊断是2、为明确诊断,进一步
- 恶性肿瘤向肺内转移,最易出现的X线表现有
- 1、从患者的胸部X线片中可见哪些阳性征象
- 术前胸片示肺内球形影,术中未发现,术后2
- 下述哪些属硅酸盐肺 ( )A、石棉肺B、
- 大叶性肺炎典型的病理变化分期包括下列哪些
- 肺结核病可以见到的空洞为 ( )A、厚壁
- 下述哪种疾病,MRI诊断价值优于CTA、
- 肺纹理聚拢见于 ( )A、肺结核 B、支
- 上叶分布为主的肺纤维化见于 ( )A、过
- 胸部侧位片,纵隔的划分包括A、前纵隔B、
- 下列肺炎中X线表现为类圆形阴影且易形成空
- 下述哪项是心包积液常见的X线征象A、心脏
- 肺内进行性大块纤维化可见于 ( )A、煤
- 肺癌支气管动脉化疗的适应证为A、晚期不能
- 下列胸部疾患X线摄影位置,正确的是A、肺
- 1、首先考虑的诊断是 ( )2、进一步检
- 以下病变不会发生空洞的是A、肺脓肿B、肺
- 位于前纵隔的肿瘤有 ( )A、